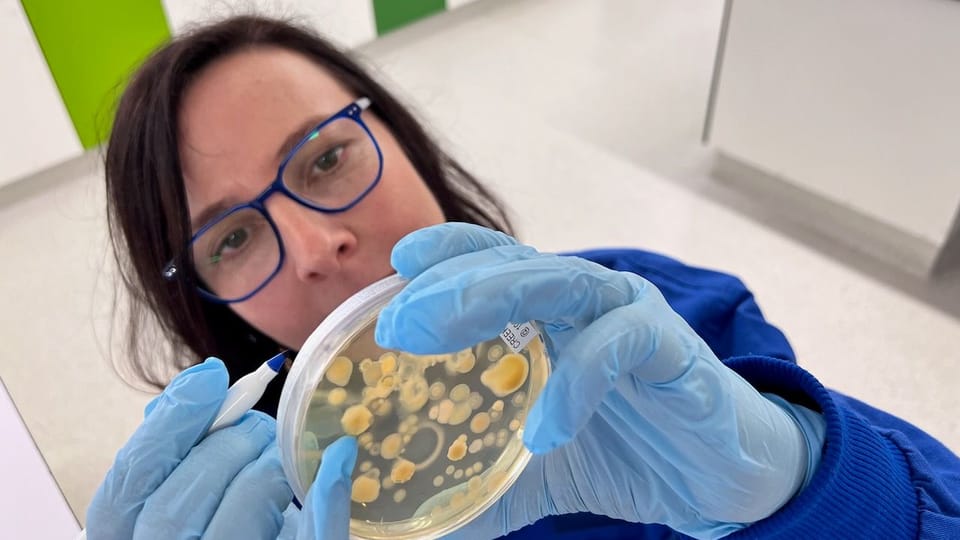

Forest_Art_Intelligence
WHAT:
Forest Art Intelligence (FAI) (2023 – ) is a long-term, living experiment in co-creating pathways between experimental art, ecological science, and Traditional Ecological Knowledges (TEK). FAI aims to understand how to develop speculative forms called ‘Art Intelligences' capable of growing and evolving their own 'ecological niches' within a regenerating forest, whilst also actively benefiting that forest’s health. Once established, these on-site artworks then become sites for public observation and interpretation of the profound intelligence of that Country - as well as the inspiration for a future touring exhibition of artworks (2027-8). The project is being developed through a collaboration with Samford Ecological Research Facility (SERF) and the Terrestrial Ecosystem Research Network (TERN). It is currently funded by Creative Australia's Experimental and Emerging Arts (2023-6), and in 2024 was supported by an ANAT Synapse Residency award (ANAT).
BACKGROUND:
In 2023 our art+science team secured unprecedented permission to restore a currently cleared block of land back to high conservation-value forest at the partner's site, Samford Ecological Research facility (SERF). After designating the forest itself as the project’s ‘meta-artwork’, during 2023–25 we began to create Art Intelligences (‘AIs’) – experimental artworks distributed across the 2-hectare self-regenerating eucalypt forest site. Some AIs were introduced (e.g. a relocated 1.5-tonne blue gum log that now hosts habitat), whilst others, already on the site, were designated as ‘AI readymades’. Slowly these Art Intelligences evolved into aesthetically compelling ‘threshold sites’ – deeply entangled with life and decay. During that time, funded consultations with First Nations creatives Jimmy Southwood and Brett Leavy (Bilby XR Labs) further revealed the transformative possibilities when human and natural intelligences collaborate meaningfully. Building on our shared understanding, Jimmy who partners with Aboriginal and Torres Strait Islander organisations Cre8tive Nations/Cre8tive Conversations, will join FAI as a key collaborator in 2027.
By 2026 the artwork site - a formerly slashed paddock - had bust back into an amazing plethora of new life - with new native tree and plant growth evident across the entire 2Ha site; confirmed through annual biodiversity surveys conducted by the team's scientists. This transformation, in part assisted by our Art Intelligences ('AIs'), underpins a future suite of on-site, guided multi-sensory art events (2027) and the development of 6 new hybrid artworks, suited to national touring (2027-8). Together they will bring human place and purpose within a forest’s transformational intelligence to public attention.
Our project’s actions, & our on-site creations are intended to directly benefit the forest through both 'performing' ecological functions, whilst also encouraging public engagement with the forest's processes of intelligent natural regrowth. (Also see the project's ANAT 2024 developmental blog, and 2025 developmental blog and the animated art installations produced as part of the research and development process. (Common Thread for ISEA 2022, Analog Intelligence for ISEA 2024 and Translucent Kinship for ANAT SPECTRA 2025 :: Reciprocity).
WHO: Collaborating Science Team: Dr David Tucker (QUT Landscape Ecologist), Dr Gabrielle Lebbink (QUT Freelance Plant and Invasion Ecologist), Dr Eleanor Velasquez (TERN Education and Training Manager at Terrestrial Ecosystem Research Network TERN Australia) and Marcus Yates (QUT/SERF Site Technician). Further supported by A/Prof Caroline Hauxwell (QUT Microbiologist and Agricultural Biotechnologist).
PARTNERS: FAI is supported by the Australian Government through Creative Australia, its arts funding and advisory body, Samford Ecological Research Facility (SERF) and the NCRIS-enabled Terrestrial Ecosystem Research Network (TERN) and QUT. In 2024 it was supported by the ANAT Synapse residency program/the Australian Network for Art and Technology (ANAT),
INITIAL OUTCOMES:
- Artwork 2 - Translucent Kinship for ANAT SPECTRA 2025 :: Reciprocity
- Artwork 1 - Analog Intelligence (2024) for ISEA 2024
- Public Outcomes: Stop on the SERF Engaging Science Trail
- Public presentation at the SERF open day, 2024
- ANAT 2024 developmental blog
- 2025 developmental blog
FURTHER DETAILS:
FAI’s project’s primary artwork outcome is a native forest slowly re-growing on Country at SERF in SEQld. Since 2023 that forest (or more correctly ‘grassy woodland biome’) has begun to recover after 100 years of being slashed back to pasture. As the forest cycles through yet unknown states of recovery, the project’s art-science team are conducting ongoing, ritual caring actions for that forest - in service of Country’s needs (e.g. inoculation of soil materials/burning/weeding and botanical surveys). Set within that forest, a range of embedded artwork outcomes are/will uncover/speak to the resonances of that Country - suggested through alternative image and narrative.
Scientific Observations
The entire site, some of its non-human inhabitants and its atmospheres above ground, are being periodically recorded/imaged - aerially and terrestrially using photo, laser and video, according to periodic and repeatable scientific protocols. Sub-surface soil sampling is also investigating the changing diversity of fungi and other microorganisms. Ambient audio of nonhumans is also being sampled across the entire site 24/7. Together all these collated, time-based, monitoring approaches are recording and assess the site’s evolution with scientific accuracy.
In 2024 the idea of Art Intelligences (AI) was further developed as follows - adding the concepts of Art Intelligence Accelerators (AIA) and Art Intelligence Interpreters (AII).
Art Intelligences (AI) = Experimental artworks, embedded within the forest site, compatible with, & allied with the profound, natural intelligences of the forest (the meta-artwork) as it repairs and re-grows. These hybrid installations across the site ‘evolve with’ and ‘learn from’ the evolving forest whilst directly benefitting its growth. AIs might also evoke awe and encourage public engagement with the forest’s fluxes of intelligent natural regrowth. AIs are placed at principal, representative sites, and therefore stand in as proxy for the entire forest development. E.g. see here.
Art Intelligence accelerators (AIA) = Additional/embellishing, creative elements added to Art Intelligences to enhance and accelerate local ecological processes – therefore intended primarily for non-humans. For example, these may add additional benefit or encouragement to certain organisms to be and become, that in turn will further aid forest recovery.
Art Intelligence interpreters (AII) = Elements that create additional layers of engagement with the AIs, and their hosting forest, intended predominantly for human audiences (art and otherwise). Art Intelligence Interpreters may be accessed both locally and/or remotely – (e.g. they may involve on-site translations in light sound & vibration and forms of online observation). AII interpreters may also draw data from the existing on-site scientific observatory instruments (e.g. scientific standards such as laser scanners, ‘acoustic observatory’ stations, veg-change cameras & carbon sequestration soil/air probes), and may also employ an analog material palette of ‘lively materials’ capable of detecting & registering changes above & below the soil in colour, light, movement & growth (including absorbent flexing woods and metals, reflective materials, sensitive litmus papers, continually circulated water & seed banks) as well as networked analog sensor systems accessible remotely.
"The world is not like a computer; computers are like the world”. Computers are part of nature: They are our creations. (James Bridle, 2022).
Hence whereas the entire site is an experimental artwork – these added elements AIs + AIAs further activate the site with AIIs then encouraging further human observation and engagement.
Resources
- Full paper about the project published by:
University Cambridge Press, Australian Journal of Environmental Education: Armstrong, K., Velasquez, E., Tucker, D., Leimbach, T., Palmer, J., & Yates, M. (2026).Towards a Critical Pedagogy of Forest Intelligence. Introducing the Forest Art Intelligence (FAI) Project. Australian Journal of Environmental Education, 1–25.https://doi.org/10.1017/aee.2025.10111
- Article about the project published by TERN (Terrestrial Ecology Research Network)
- Artwork 2 - 'Translucent Kinship' for ANAT Spectra Reciprocity:: 2025
- Artwork 1 - 'Analog Intelligence' (2024) for ISEA 2024
- Public Outcomes: Stop on the SERF Engaging Science Trail
- Public presentation at the SERF open day, 2024
- ANAT 2024 developmental blog
- 2025 developmental blog